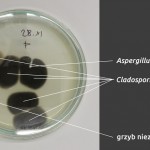
opis_760
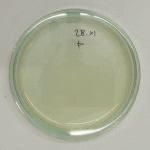
200

Autor: lab_kons, 10-12-2014

Na szalkę pobrano próbę (20 l) z powietrza atmosferycznego (tło). Podłoże MEA.
Zdjęcia robiono przez 10.
Autor: lab_kons, 02-10-2014
Celem kontroli mikrobiologicznej powietrza jest określenie ilości jednostek tworzących kolonie w jednostce objętości i konfrontacja otrzymanych wyników z przyjętymi założeniami oraz poprzednimi wynikami dla danego pomieszczenia i tła czyli powietrza atmosferycznego. Wyniki dostarczają informacji o jakości powietrza, czyli poziomu bezpieczeństwa obiektów i personelu.
W BN stosowane są następujące schematy pobierania prób metodą impakcyjną przy użyciu próbnika MAS-100Eco (firmy MERCK):
- badania tła – w 2 miejscach na zewnątrz budynków 3 próby w linii pionowej na 3 różnych wysokościach (ok. 0,4, 1,4 i 2,4m) nad gruntem. Badania wykonywane są codziennie
- badania pomieszczeń małych – do ok. 50m kwadratowych powierzchni – 3 próby na 3 różnych wysokościach (ok. 0,4, 1,4 i 2,4m) po przekątnej pomieszczenia (
- badania pomieszczeń powyżej 50 m kwadratowych powierzchni – 3 próby w linii pionowej na 3 różnych wysokościach (ok. 0,4, 1,4 i 2,4m) w co najmniej 2 punktach na przekątnej pomieszczenia tak, aby odległości punktów badań od siebie, a skrajnych także od ścian były równe. Ilość punktów jest dobierana indywidualnie do pomieszczenia, w praktyce odległości miedzy punktami na przekątnej wynoszą od 3 do 10m (przy dużych i długich pomieszczeniach), z zachowaniem granicy górnej 30 szalek na pomieszczenie (wtedy odległości mogą być zwiększone)
Autor: lab_kons, 11-08-2014